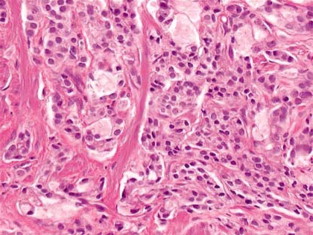
Tipos de cáncer de próstata

Publicado enPatología
¿Qué estudia la patología clínica?
Es esencial comprender de manera amplia el proceso de la enfermedad, para que los médicos y los cirujanos reconozcan, diagnostiquen, y traten todas las enfermedades con precisión y competencia. Con…